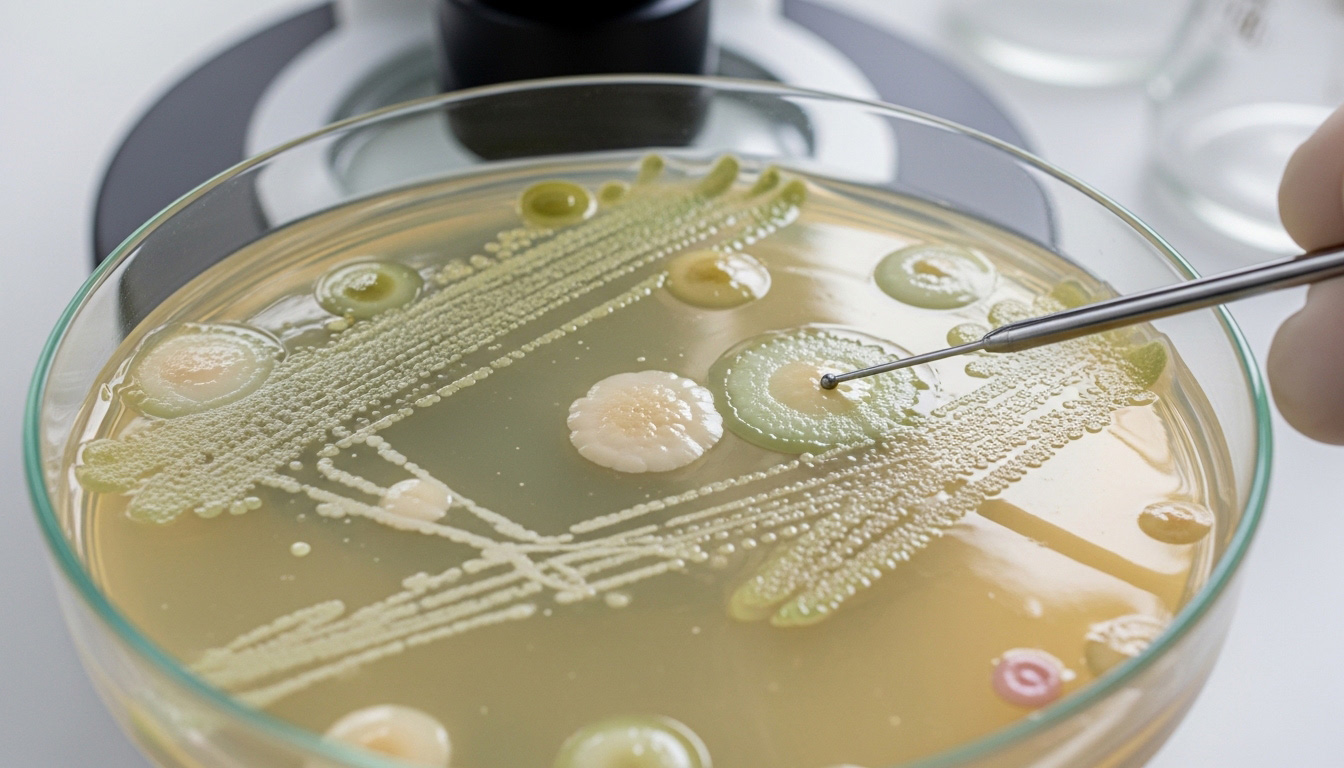
img-responsive

Antibiotska rezistencija – izazov savremene medicine i uloga zdravstvenih radnika
Teme
Antibiotska rezistencija – izazov savremene medicine i uloga zdravstvenih radnika
AI u zdravstvu pod lupom: Da li je veštačka inteligencija zaista pouzdanija od internet pretrage?
Otkrića iz imunologije nagrađena Nobelom 2025
Najnoviji trendovi u lečenju hroničnih bolesti
Nacionalno istraživanje zdravlja Srbije 2025: Put ka boljem razumevanju zdravlja nacije
Kako se pripremiti za praktičnu nastavu u bolnici
Prvi kongres MIND – Medical Innovation through Digital Transformation u Beogradu
Saveti za buduće medicinske sestre – šta treba znati pre upisa škole?
Medicinska dostignuća iz 2024. godine koja menjaju budućnost zdravlja
Antibiotska rezistencija predstavlja jedan od najvećih problema današnjice, koji direktno utiče na uspešnost lečenja brojnih infekcija. U svakodnevnoj praksi, medicinska sestra ima važnu ulogu u pravilnoj primeni terapije, edukaciji pacijenata i praćenju njihovog stanja, čime doprinosi sprečavanju razvoja rezistencije. Nepravilna upotreba antibiotika može dovesti do toga da bakterije postanu otporne, što dodatno komplikuje proces lečenja.
Sličnu odgovornost ima i medicinska sestra-tehničar, koji učestvuje u sprovođenju terapije i vodi računa o pravilnom doziranju i vremenskom razmaku između lekova. Njihova uloga je ključna u očuvanju efikasnosti antibiotika, jer pravilna primena smanjuje mogućnost da bakterije razviju otpornost. Upravo zbog toga, edukacija medicinskog kadra ima veliki značaj u borbi protiv ovog globalnog problema.
Šta je antibiotska rezistencija?
Antibiotska rezistencija nastaje kada bakterije razviju sposobnost da prežive dejstvo antibiotika koji su ranije bili efikasni u njihovom uništavanju. To znači da standardne terapije postaju manje delotvorne, a infekcije duže traju i teže se leče. U nekim slučajevima, rezistentne bakterije mogu izazvati ozbiljne komplikacije, pa čak i životno ugrožavajuća stanja.
Ovaj proces je prirodan fenomen, ali se značajno ubrzava usled nepravilne i prekomerne upotrebe antibiotika, kako u medicini, tako i u veterini i poljoprivredi.
Glavni uzroci razvoja rezistencije
Jedan od osnovnih razloga za razvoj antibiotske rezistencije jeste neodgovorno korišćenje lekova. To uključuje uzimanje antibiotika bez konsultacije sa lekarom, prekid terapije pre vremena ili korišćenje antibiotika za virusne infekcije, gde oni nemaju efekta.
Pored toga, važan faktor je i nepravilno propisivanje terapije, kao i nedovoljna edukacija pacijenata. Kada se antibiotici koriste bez jasne potrebe, bakterije imaju veću šansu da razviju mehanizme odbrane i postanu otporne.
Posledice antibiotske rezistencije
Posledice ovog problema su brojne i ozbiljne. Infekcije koje su nekada bile lako izlečive postaju dugotrajne i komplikovane. To dovodi do dužeg boravka u bolnici, većih troškova lečenja i povećanog rizika od komplikacija.
U najtežim slučajevima, antibiotska rezistencija može dovesti do situacija u kojima više ne postoji efikasan lek za određene bakterijske infekcije. Ovo predstavlja veliki izazov za zdravstveni sistem širom sveta.
Kako sprečiti razvoj rezistencije?
Prevencija antibiotske rezistencije zahteva zajednički napor zdravstvenih radnika i pacijenata. Ključne mere uključuju odgovorno korišćenje antibiotika, poštovanje preporuka lekara i završavanje propisane terapije u celosti.
Edukacija ima posebno važnu ulogu. Zdravstveni radnici, uključujući medicinske sestre i tehničare, treba da informišu pacijente o pravilnoj upotrebi lekova i rizicima nepravilnog lečenja. Takođe, higijena, redovno pranje ruku i sprečavanje širenja infekcija doprinose smanjenju potrebe za antibioticima.
Važnost zajedničkog delovanja u borbi protiv rezistencije
Antibiotska rezistencija je ozbiljan globalni problem koji zahteva odgovoran pristup i kontinuiranu edukaciju. Uloga zdravstvenih radnika je od ključnog značaja, jer svojim znanjem i praksom mogu značajno uticati na pravilnu primenu terapije. Samo zajedničkim naporima moguće je očuvati efikasnost antibiotika i obezbediti uspešno lečenje i u budućnosti.